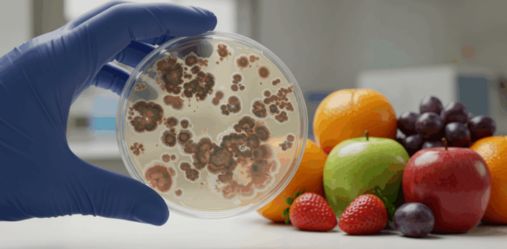
product-image
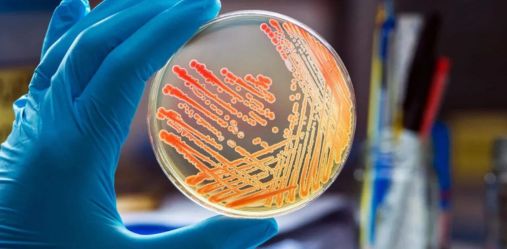
product-image

Food Services
Contaminants Testing
Our contaminant testing identifies pesticides, mycotoxins, organic pollutants, dioxins, and other possible food hazards.
Read More

Food Contact Materials Testing
Our team tests and verifies compliance of materials meant to contact food throughout the entire supply chain.
Read More
Microbiological Testing
Our microbiology testing supports clients in identifying specific microorganisms present in their products.
Read More

Nutritional Testing
We provide nutritional testing to verify product nutrient levels and meet essential regulatory and labeling standards.
